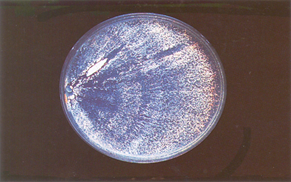
image.png
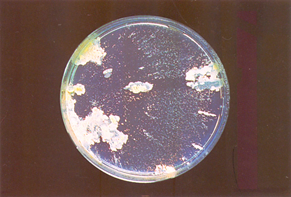
image.png

Pycnoporus sanguineus Macroscopic Description:1 wk growth: Colony radius 35-39mm. Mat white. Advancing zone even. Aerial mycelium pellicular. 2 wk growth: Plates covered. Mat white. Aerial mycelium absent to pellicular, around inoculum crustose composed of some orange spots. 6 wk growth: Plates covered. Mat white to orange. Aerial mycelium pellicular, cmstose around inoculum. Odor fragrant. Agar unchanged. Not fruiting.
Pycnoporus sanguineus Microscopic Description:Hyphal system dimitic. Advancing hyphae colorless, 2-3 μm diam., thin-walled, nodose-septate. Aerial skeletal hyphae colorless, 2-2.5 μm diam., sparsely branched; aerial generative hyphae colorless, partly orange-tinted, 1.5-3 μm diam., thin-walled, nodose-septate, sparsely branched. Anthroconidia numerous, colorless, 3-5 x 1.5-2 μm diam., thin-walled. Submerged hyphae colorless, partly orange-tinted, 1.5-6.5 μm diam., thin-walled, nodose-septate, moderately branched. Crystals in the agar.

Pycnoporus sanguineus Fruiting bodies:
Pycnoporus sanguineus Culture after 2 wk of growth on 1.5% MEA at 25 °C
Pycnoporus sanguineus Culture after 6 wk of growth on 1.5% MEA at 25 °C

Pycnoporus sanguineus growth rate in different temperatures.。
Pycnoporus sanguineus Notes:Sporophore contains polyporin which proves effective against bacteria. Sporophore also inhibits parenchymatous tumour in animals. It promotes the growth of muscles, invigorates vitality and blood circulation, reduced damp phlegm, expels rheumatism and stops itching, regulates the flow of vital energy and stops bleeding (Ying et al., 1987).

发表评论